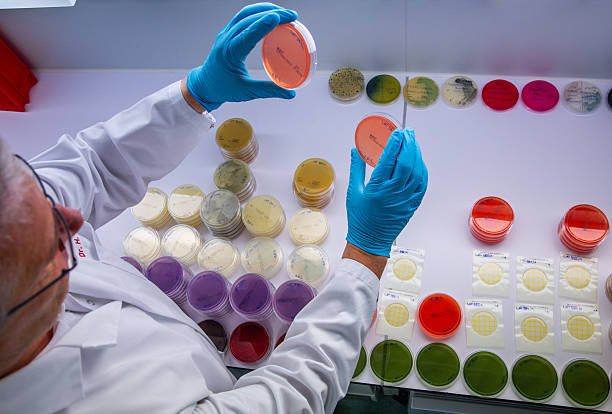

এই অংশে ক্লাস ১০-এর পদার্থবিজ্ঞানের গুরুত্বপূর্ণ অধ্যায় পরমাণুর নিউক্লিয়াস থেকে তেজস্ক্রিয়তা (7.1) বিষয়ের উপর গুরুত্বপূর্ণ প্রশ্ন ও উত্তর সংগ্রহ করা হয়েছে। এখানে WB Madhyamik এবং অন্যান্য বোর্ড পরীক্ষার প্রস্তুতির জন্য সম্ভাব্য গুরুত্বপূর্ণ প্রশ্নগুলি সংকলিত হয়েছে। ছাত্রছাত্রীরা এই অংশ থেকে তেজস্ক্রিয়তা কী, এর ধরণ, বৈশিষ্ট্য, উদাহরণ এবং এর প্রয়োগ সম্পর্কে পরিষ্কার ধারণা পাবে। পাশাপাশি পরীক্ষায় আসা বহুনির্বাচনী প্রশ্ন (MCQ), সংক্ষিপ্ত উত্তরধর্মী প্রশ্ন এবং বিশ্লেষণধর্মী প্রশ্নের মাধ্যমে অধ্যায়টির মূল অংশ সহজে মনে রাখার সুযোগ তৈরি হবে। এই প্রশ্নোত্তর গাইডটি শুধু পরীক্ষার প্রস্তুতিকে সহজ করে তুলবে না, বরং পাঠ্যবইয়ের বিষয়বস্তুকে আরও স্পষ্ট ও গভীরভাবে বুঝতে সহায়তা করবে। নিয়মিত অনুশীলন করলে এই অংশ থেকে ভাল নম্বর পাওয়া একেবারেই সহজ।

1) MCQ প্রশ্ন ও উত্তর: সঠিক উত্তর টি নির্বাচন করো(পরমাণুর নিউক্লিয়াস )
প্রশ্ন : তেজস্ক্রিয়তা আবিষ্কার করেন – নিউটন/ বেকারেল / থমসন / ওয়াটসন
উত্তর : বেকারেল।
প্রশ্ন : তেজস্ক্রিয়তা একটি -রাসায়নিক ঘটনা/ ইলেকট্রনীয় ঘটনা /নিউক্লিয় ঘটনা /কোনটি নয় ।
উত্তর : নিউক্লিয় ঘটনা ।
প্রশ্ন: কোনটি তেজস্ক্রিয় তা পরিমাপের একক নয়— কুরি / বেকারেল /রাদারফোর্ড/ ফার্মি ।
উত্তর : ফার্মি।
প্রশ্ন : X- রশ্মির বিকিরণের ফলে মৌলের পারমাণবিক সংখ্যা— একই থাকে/ 2 একক কমে/ 2 একক বাড়ে / 4 একক কমে।
উত্তর : একই থাকে।
প্রশ্ন: তেজস্ক্রিয় মৌল গুলিতে নিউট্রন ও প্রোটন সংখ্যার অনুপাত 1.5 -এর — সমান / বেশি /কম /কোনোটি নয় ।
উত্তর: বেশি ।
প্রশ্ন: তড়িৎ ক্ষেত্র দ্বারা বিচ্যুত হয় না —- পজিট্রন / γ- রশ্মি / β- রশি / α- রশি ।
উত্তর : γ – রশ্মি।
প্রশ্ন: বিভিন্ন প্রকার তেজস্ক্রিয় বিকিরনের মধ্যে তড়িৎচুম্বকীয় তরঙ্গ হল -α-রশ্মি / β -রশি / γ-রশ্মি/ X -রশ্মি
উত্তর: γ -রশ্মি ।
প্রশ্ন: পুরা তাত্ত্বিক বয়স নির্ণয় করতে কোন তেজস্ক্রিয় মৌলটি ব্যবহৃত হয়?
– কার্বন / রেডিয়াম / ইউরেনিয়াম / কোবাল্ট ।
উত্তর: কার্বন ।
প্রশ্ন: ক্যান্সার চিকিৎসায় ব্যবহৃত হয়– সোডিয়াম/ তেজস্ক্রিয় Na / তেজস্ক্রিয় Co / পোলোনিয়াম।
উত্তর: তেজস্ক্রিয় Co ।
2 ) শূন্যস্থান পূরণ কর । (পরমাণুর নিউক্লিয়াস)
প্রশ্ন: তেজস্ক্রিয় মৌল থেকে নির্গত B-রশ্মি হল____________কণার স্রোত ।
উত্তর: ইলেকট্রন
প্রশ্ন: তেজস্ক্রিয় মৌলের যে পরমাণুর তেজস্ক্রিয় বিঘটন হয় তাকে________ বলে।
উত্তর: জনক পরমাণু
প্রশ্ন: α -কনা নির্গত হয় পরমাণুর________ থেকে।
উত্তর: নিউক্লিয়াস ।
প্রশ্ন: ইউরেনিয়ামোত্তর সকল মৌলই _______
উত্তর: তেজস্ক্রিয়।

দু- একটি শব্দে উত্তর দাও।(পরমাণুর নিউক্লিয়াস)
প্রশ্ন: একটি প্রাকৃতিক তেজস্ক্রিয় মৌলের নাম লেখ
উত্তর : ইউরেনিয়াম।
প্রশ্ন: একটি তরল প্রাকৃতিক তেজস্ক্রিয় মৌলের নাম লেখ।
উত্তর: ফ্রান্সিয়াম (Fr)
প্রশ্ন: α, β, y-রশিকে ভেদন ক্ষমতার উর্ধক্রমে সাজাও
উত্তর: α< B<γ
প্রশ্ন: কোন তেজস্ক্রিয় রশ্মির গতিশক্তি সবচেয়ে কম।
উত্তর:α -রশ্মির
প্রশ্ন: তেজস্ক্রিয় তার SI (এসআই) একক কি
উত্তর: বেকারেল
প্রশ্ন: কোন তেজস্ক্রিয় রশ্মি ধনাত্মক তড়িৎগ্রস্থ কণার স্রোত।
উত্তর: α-রশ্মি
প্রশ্ন: তেজস্ক্রিয় রশ্মি গুলির মধ্যে কোনটি বেশি তড়িৎ আধানযুক্ত।
উত্তর: α -রশ্মি
প্রশ্ন: আধান বিহীন তেজস্ক্রিয় রশ্মীর নাম লেখ
উত্তর: γ -রশ্মি
প্রশ্ন: a -রশ্মির কোন আধান যুক্ত কনার স্রোত?
উত্তর: ধনাত্মক আধানযুক্ত হিলিয়াম আয়নের
প্রশ্ন: γ -রশির আধান কোন প্রকৃতির?
উত্তর: নিস্তড়িত
প্রশ্ন: β -রশির আধানের প্রকৃতি কিরূপ?
উত্তর: ঋণাত্মক
প্রশ্ন: β -রশিতে প্রতিটি কণার উৎস কি?
উত্তর: নিউক্লিয়াস
প্রশ্ন: কোন তেজস্ক্রিয় পরমাণু থেকে কোন তেজস্ক্রিয় রশ্মি নির্গত হলে পারমাণবিক সংখ্যা অপরিবর্তিত থাকে?
উত্তর: γ -রশ্মি
প্রশ্ন: কৃত্রিম তেজস্ক্রিয়তাই কোন বিশেষ কন্যা নির্গত হয়?
উত্তর: নিউট্রিনো
বোধ মূলক প্রশ্নোত্তর।(পরমাণুর নিউক্লিয়াস)
প্রশ্ন: ‘ তেজস্ক্রিয়তা একটি নিউক্লিয় ঘটনা ‘ —- ব্যাখ্যা কর
উত্তর: তেজস্ক্রিয় মৌল যৌগ গঠন করলেও তেজস্ক্রিয়তা প্রদর্শনে সক্ষম। তেজস্ক্রিয় মৌলের নিউক্লিয়াসের ভেতর অবিরাম নিউট্রন কণা, প্রোটন ও ইলেকট্রন কোন রূপান্তরিত হয়। তেজস্ক্রিয় বিঘটনে যে বিপুল পরিমাণ শক্তি নির্গত হয় তা নিউক্লিয়াসের মতো ভারী অংশ থেকে মুক্ত হয়। এর থেকে বলা যায় তেজস্ক্রিয়তা একটি নিউক্লিয় ঘটনা ।
প্রশ্ন: তেজস্ক্রিয়তার প্রচলিত ও SI একক গুলি লেখ ।
উত্তর: তেজস্ক্রিয় তার প্রচলিত একক হল কুরি এবং তেজস্ক্রিয়তার SI একক হল বেকারেল ।
প্রশ্ন: তেজস্ক্রিয়তার বিভিন্ন ব্যবহার গুলি আলোচনা করো ।
উত্তর: তেজস্ক্রিয় রেডিয়াম থেকে নির্গত বিকিরণের সাহায্যে ক্যান্সার আক্রান্ত কোষ ধ্বংস করা হয়।
পৃথিবীর বয়স নির্ণয় করা হয় তেজস্ক্রিয় ইউরেনিয়ামের সাহায্যে ।
প্রশ্ন: কোন তেজস্ক্রিয় পরমাণু থেকে একটি a- কণা নির্গত হলে অপত্য পরমাণুর পারমাণবিক সংখ্যা ও ভর সংখ্যা কিভাবে পরিবর্তিত হয় ।
উত্তর: আপডেট করা হবে ।
প্রশ্ন: প্রাকৃতিক তেজস্ক্রিয়তা কাকে বলে?
উত্তর : আপডেট করা হবে।
প্রশ্ন: তেজস্ক্রিয় বিঘটন কি ?
উত্তর: আপডেট করা হবে।
প্রশ্ন: তেজস্ক্রিয় বিঘটনের বৈশিষ্ট্য গুলি লেখ।
উত্তর: আপডেট করা হবে ।
প্রশ্ন: প্রাকৃতিক তেজস্ক্রিয় সমস্থানিক কাকে বলে?
উত্তর : আপডেট করা হবে।
প্রশ্ন: জনক ও দুহিতা কেন্দ্র বলতে কি বোঝায়?
উত্তর : আপডেট করা হবে ।
প্রশ্ন: তেজস্ক্রিয় রশ্মি নির্গমনে কিভাবে নতুন নিউক্লিয়ার সৃষ্টি হয়।
উত্তর: আপডেট করা হবে।